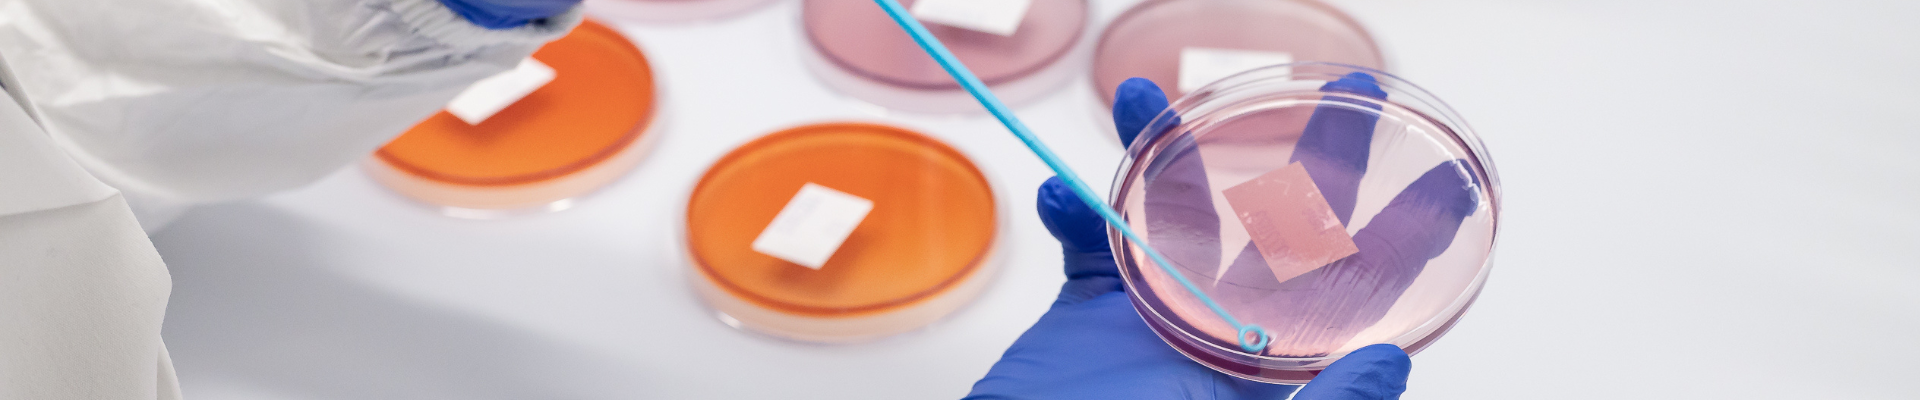

Microbiological Quality Control Testing
Trusted Partner for Non-Sterile Microbiological QC
Microbial control is essential for non-sterile pharmaceuticals, medical devices and combination products. Cormica delivers microbiological quality control testing that aligns with USP <61> and USP <62>, as well as Ph. Eur. 2.6.12 / 2.6.13 and other international expectations, so your products meet the requirements of authorities such as the FDA and MHRA.
Operating under GMP and GLP, our microbiology teams provide reliable data and practical guidance that support informed decisions on product release and lifecycle management. Our values, including doing what is right and working together, shape how we collaborate with you, from method development through to routine QC and investigations.

Your Partner in Microbial Quality Control Testing Services

Microbial Enumeration Testing (TAMC/TYMC)
Performed to determine total aerobic microbial count (TAMC) and total yeast and mould count (TYMC) in non-sterile products, aligned with USP <61>, Ph. Eur. 2.6.12, and BP requirements.

Specified Microorganism Detection (Absence of Objectionable Organisms)
Assessment of non-sterile products for the absence of objectionable organisms such as E. coli, Pseudomonas aeruginosa, Salmonella spp., Staphylococcus aureus, etc., following USP <62>, Ph. Eur. 2.6.13, and BP guidelines.

Bioburden Testing (Pre-sterilisation Microbial Load)
Measurement of viable microorganisms present before sterilisation, commonly performed using ISO 11737-1 and aligned with pharmacopeial expectations for process validation.

Preservative Efficacy / Antimicrobial Effectiveness Testing (AET/PET)
Evaluation of antimicrobial preservative performance over time in accordance with USP <51>, Ph. Eur. 5.1.3, and BP standards.

Method Suitability / Validation for QC Testing
Adaptation and validation of pharmacopeial QC methods to specific product formulations, in accordance with USP, Ph. Eur., and ISO guidance.

Potable and Purified Water Microbiological Testing
Microbial monitoring of water systems used in production, performed in accordance with USP <1231>, Ph. Eur. 2.6.12/2.6.13, EU GMP Chapter 7, and applicable ISO guidance.

Growth Promotion Testing (Media Suitability Testing)
Verification of culture media performance to support USP <61>, <62>, USP <71>, and Ph. Eur. 2.6.1 microbiological methods.
Environmental Swab Enumeration
Quantitative assessment of microorganisms on manufacturing surfaces as part of facility hygiene programs, in alignment with ISO 14644, EU GMP Annex 1, and USP <1116> guidance.
Laboratories near you, supporting global product success
With accredited laboratories in the UK, EU and US, we support pharmaceutical, medical device and combination product manufacturers worldwide. Local support combined with global quality, delivered by teams who understand your regulatory requirements.



Potable Water Testing
We can conduct testing on water from manufacturing facilities either as part of routine Environmental Monitoring sampling at your site, or through client samples sent directly to us.
Testing of potable water can determine the levels of microorganisms present, if growth is obtained, morphologies are then analysed by trained scientists to report whether growth is similar to that of the target organism.
The types of testing we can offer for potable water samples are as follows:
- TVC at 37C
- TVC at 22C
- Escherichia coli
- Total coliforms
- Pseudomonas aeruginosa
- Enterococci and other faecal organisms
- Clostridium perfringens

Enumeration of environmental swab testing
We can perform analysis of swab samples taken directly from a clients facility either from their routine Environmental Monitoring requirements or if they encounter a contamination issue and are swabbing their facility to investigate the source of contamination.
The swab is then transported in a suitable transport medium and received at Cormica to undergo analysis following plate count procedures.











